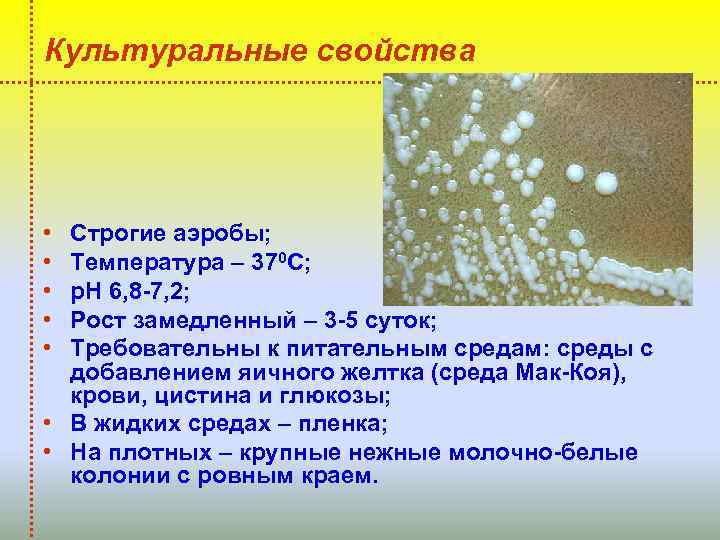
Культуральные свойства • • • Строгие аэробы; Температура – 370 С; р. Н 6,

856832.ppt
- Количество слайдов: 63
 СРС на тему: ЗООНОЗНЫЕ ИНФЕКЦИЙ Подготовил: Аманов С. E. Группа: 204. Факультет: медико-профилактического дела.
СРС на тему: ЗООНОЗНЫЕ ИНФЕКЦИЙ Подготовил: Аманов С. E. Группа: 204. Факультет: медико-профилактического дела.
 План презентации: 1. 2. 3. 4. 5. Понятие о зоонозах. Возбудитель сибирской язвы. Возбудитель чумы. Возбудители бруцеллеза. Возбудитель туляремии. Список литертуры
План презентации: 1. 2. 3. 4. 5. Понятие о зоонозах. Возбудитель сибирской язвы. Возбудитель чумы. Возбудители бруцеллеза. Возбудитель туляремии. Список литертуры
 Зоонозы (от греч. zoon – животное, nosos – болезнь) – это заболевания, при которых источником инфекции являются животные, служащие единственным резервуаром возбудителя в природе. • • сибирская язва; чума; бруцеллез; туляремия; псевдотуберкулез; ящур; лептоспироз; сап и т. д.
Зоонозы (от греч. zoon – животное, nosos – болезнь) – это заболевания, при которых источником инфекции являются животные, служащие единственным резервуаром возбудителя в природе. • • сибирская язва; чума; бруцеллез; туляремия; псевдотуберкулез; ящур; лептоспироз; сап и т. д.
 Сибирская язва (углевик) – это инфекционное зоонозное заболевание, вызываемое Bacillus anthracis, характеризующееся тяжелой интоксикацией, лихорадкой и протекающее в кожной, легочной и кишечной формах.
Сибирская язва (углевик) – это инфекционное зоонозное заболевание, вызываемое Bacillus anthracis, характеризующееся тяжелой интоксикацией, лихорадкой и протекающее в кожной, легочной и кишечной формах.
 Историческая справка • 1788 г. : С. С. Андреевский – название «сибирская язва» , единство этиологии у людей и животных; • 1876 г. : Р. Кох – чистая культура; • 1881 г. : Л. Пастер – живая вакцина.
Историческая справка • 1788 г. : С. С. Андреевский – название «сибирская язва» , единство этиологии у людей и животных; • 1876 г. : Р. Кох – чистая культура; • 1881 г. : Л. Пастер – живая вакцина.
 Таксономия • Семейство – Bacillaceae • Род – Bacillus • Вид – Bacillus anthracis (от греч. аnthrax – уголек)
Таксономия • Семейство – Bacillaceae • Род – Bacillus • Вид – Bacillus anthracis (от греч. аnthrax – уголек)
 Морфология • • Палочки с обрубленными концами; Размеры – 3 -5× 1 -1, 2 мкм; Жгутики отсутствуют; Образуют макрокапсулу полипептидной природы (в организме человека, животных, на питательных средах с кровью); • Формируют центрально расположенные овальной формы споры.
Морфология • • Палочки с обрубленными концами; Размеры – 3 -5× 1 -1, 2 мкм; Жгутики отсутствуют; Образуют макрокапсулу полипептидной природы (в организме человека, животных, на питательных средах с кровью); • Формируют центрально расположенные овальной формы споры.
 Морфология • Грамположительные; • В мазках – цепочками ( «бамбуковая трость» ); • Обработка пенициллином – цепочки, состоящих из протопластов ( «жемчужное ожерелье» ); • По Ожешко – споры красного цвета; • По Бури-Гинсу – капсула.
Морфология • Грамположительные; • В мазках – цепочками ( «бамбуковая трость» ); • Обработка пенициллином – цепочки, состоящих из протопластов ( «жемчужное ожерелье» ); • По Ожешко – споры красного цвета; • По Бури-Гинсу – капсула.
 Культуральные свойства • • • Факультативный анаэроб; Оптимальная температура – 35 -370 С; р. Н 7, 2 -7, 6; Хорошо растет на обычных питательных средах; Через 17 -24 часа – серебристые крупные зернистые колонии, от краев пучки нитей ( «голова Медузы» , «львиная грива» ).
Культуральные свойства • • • Факультативный анаэроб; Оптимальная температура – 35 -370 С; р. Н 7, 2 -7, 6; Хорошо растет на обычных питательных средах; Через 17 -24 часа – серебристые крупные зернистые колонии, от краев пучки нитей ( «голова Медузы» , «львиная грива» ).
 Культуральные свойства • На бульоне – ватные хлопья, без помутнения среды; • При посеве уколом в желатин – «перевернутая елочка» ; • На кровяном агаре гемолиза не дает.
Культуральные свойства • На бульоне – ватные хлопья, без помутнения среды; • При посеве уколом в желатин – «перевернутая елочка» ; • На кровяном агаре гемолиза не дает.
 Биохимическая активность • Ферментирует сахара до кислоты без газа; • • • Реакция Фогес-Проскауэра +; Разжижает желатин; Восстанавливает нитраты; Образует H 2 S и аммиак; Индол не образует; Пептонизирует молоко.
Биохимическая активность • Ферментирует сахара до кислоты без газа; • • • Реакция Фогес-Проскауэра +; Разжижает желатин; Восстанавливает нитраты; Образует H 2 S и аммиак; Индол не образует; Пептонизирует молоко.
 Антигенная структура • О-антиген – соматический, ЛПС КС, термостабильный, группоспецефический (реакция колцепреципитации по Асколи). • К-антиген – капсульный, полипептид, видоспецифический. • Протективный антиген – белковый токсин (выраженные иммуногенные свойства).
Антигенная структура • О-антиген – соматический, ЛПС КС, термостабильный, группоспецефический (реакция колцепреципитации по Асколи). • К-антиген – капсульный, полипептид, видоспецифический. • Протективный антиген – белковый токсин (выраженные иммуногенные свойства).
 Факторы патогенности Токсины: экзотоксин – состоит из 3 компонентов: Ø Протективный антиген – взаимодействует с мембранами клеток, опосредует активность других компонентов. Ø Летальный фактор ( «мышиный токсин» ) – цитотоксический эффект. Ø Отечный фактор – повышает ц. АМФ, вызывая развитие отеков. По отдельности токсическое действие не проявляют! • Ферменты: протеазы. • Структурные и химические компоненты клетки: капсула, споры.
Факторы патогенности Токсины: экзотоксин – состоит из 3 компонентов: Ø Протективный антиген – взаимодействует с мембранами клеток, опосредует активность других компонентов. Ø Летальный фактор ( «мышиный токсин» ) – цитотоксический эффект. Ø Отечный фактор – повышает ц. АМФ, вызывая развитие отеков. По отдельности токсическое действие не проявляют! • Ферменты: протеазы. • Структурные и химические компоненты клетки: капсула, споры.
 Резистентность • Вегетативные формы малоустойчивы. • Споры: Ø 1000 С – 1 час; Ø автоклавирование (1200 С) – 15 -20 минут; Ø сухой жар (1400 С) – 2 -3 часа; Ø дезинфицирующие средства – 6 -8 часов; Ø в почве, в шкурах – десятилетиями. • Чувствительны к стрептомицину, левомицетину, тетрациклину.
Резистентность • Вегетативные формы малоустойчивы. • Споры: Ø 1000 С – 1 час; Ø автоклавирование (1200 С) – 15 -20 минут; Ø сухой жар (1400 С) – 2 -3 часа; Ø дезинфицирующие средства – 6 -8 часов; Ø в почве, в шкурах – десятилетиями. • Чувствительны к стрептомицину, левомицетину, тетрациклину.
 Эпидемиология • Зооноз. • Источник инфекции – больные животные (выделяют с мочой, испражнениями). • Пути передачи: Ø Непрямой контактный; Ø Алиментарный; Ø Воздушно-капельный; Ø Воздушно-пылевой; Ø Трансмиссивный путь.
Эпидемиология • Зооноз. • Источник инфекции – больные животные (выделяют с мочой, испражнениями). • Пути передачи: Ø Непрямой контактный; Ø Алиментарный; Ø Воздушно-капельный; Ø Воздушно-пылевой; Ø Трансмиссивный путь.
 Патогенез и клинические особенности Инкубационный период – 2 -6 суток. • Кожная форма: пятно папула везикула с серозно- геморрагическим содержимым черный увеличивающийся в размерах струп (уголек), окружен инфильтратом. • Легочная форма. • Кишечная форма.
Патогенез и клинические особенности Инкубационный период – 2 -6 суток. • Кожная форма: пятно папула везикула с серозно- геморрагическим содержимым черный увеличивающийся в размерах струп (уголек), окружен инфильтратом. • Легочная форма. • Кишечная форма.
 Иммунитет Постинфекционный иммунитет – антимикробный и антитоксический напряженный, развивается ГЗТ.
Иммунитет Постинфекционный иммунитет – антимикробный и антитоксический напряженный, развивается ГЗТ.
 Микробиологическая диагностика Исследуемый материал – содержимое везикул, пустул, отделяемое карбункулов, язв, тканевой выпот, мокрота, испражнения, рвотные массы, кровь, трупный материал, от животных – кожа, шерсть. 1. 2. 3. 4. Бактериоскопический метод. Бактериологический метод (основной). Биологический. Серологический – РПГА, РИФ, реакция кольцеприципитации по Асколи. 5. Аллергологический – проба с антраксином. 6. Молекулярно-биологический метод – ПЦР.
Микробиологическая диагностика Исследуемый материал – содержимое везикул, пустул, отделяемое карбункулов, язв, тканевой выпот, мокрота, испражнения, рвотные массы, кровь, трупный материал, от животных – кожа, шерсть. 1. 2. 3. 4. Бактериоскопический метод. Бактериологический метод (основной). Биологический. Серологический – РПГА, РИФ, реакция кольцеприципитации по Асколи. 5. Аллергологический – проба с антраксином. 6. Молекулярно-биологический метод – ПЦР.
 Специфическая профилактика. Вакцинация по эпидпоказаниям: • живой сибиреязвенной сухой вакциной СТИ; • комбинированной вакциной СТИ+протективный антиген. Специфическое лечение – противосибиреязвенная сыворотка и иммуноглобулин.
Специфическая профилактика. Вакцинация по эпидпоказаниям: • живой сибиреязвенной сухой вакциной СТИ; • комбинированной вакциной СТИ+протективный антиген. Специфическое лечение – противосибиреязвенная сыворотка и иммуноглобулин.
 Чума – острое антропозоонозное инфекционное заболевание, характеризующееся тяжелой интоксикацией, специфическим поражением лимфоузлов с развитием септицемии и тенденцией к эпидемическому и пандемическому распространению.
Чума – острое антропозоонозное инфекционное заболевание, характеризующееся тяжелой интоксикацией, специфическим поражением лимфоузлов с развитием септицемии и тенденцией к эпидемическому и пандемическому распространению.
 Историческая справка • 1894 г. : А. Иерсен и Ш. Китазато – обнаружили возбудителя чумы.
Историческая справка • 1894 г. : А. Иерсен и Ш. Китазато – обнаружили возбудителя чумы.
 Таксономия • • Семейство – Enterobacteriaceae Триба – Yersiniae Род – Yersinia Вид – Yersinia pestis
Таксономия • • Семейство – Enterobacteriaceae Триба – Yersiniae Род – Yersinia Вид – Yersinia pestis
 Морфология • Палочка овоидной формы, вздутая по середине ( «бочонок» ); • Размеры – 0, 3 -0, 7× 1 -2 мкм; • Грамотрицательные; • Окрашиваются биполярно; • В мазках – цепочками или беспорядочно; • Образуют нежную капсулу (в организме человека, животных, на кровяных средах при 370 С); • Спор, жгутиков не имеют.
Морфология • Палочка овоидной формы, вздутая по середине ( «бочонок» ); • Размеры – 0, 3 -0, 7× 1 -2 мкм; • Грамотрицательные; • Окрашиваются биполярно; • В мазках – цепочками или беспорядочно; • Образуют нежную капсулу (в организме человека, животных, на кровяных средах при 370 С); • Спор, жгутиков не имеют.
 Культуральные свойства • • • Факультативные анаэробы. Оптимальная температура – 28 -300 С. р. Н – 6, 9 -7, 2. Хорошо растут на простых питательных средах. Жидкие среды – через 48 час. пленка со спускающимися вниз нитями ( «сталактитовый рост» ).
Культуральные свойства • • • Факультативные анаэробы. Оптимальная температура – 28 -300 С. р. Н – 6, 9 -7, 2. Хорошо растут на простых питательных средах. Жидкие среды – через 48 час. пленка со спускающимися вниз нитями ( «сталактитовый рост» ).
 Культуральные свойства Плотные питательные среды – три стадии роста: Ø Молодые колонии – через 10 -12 час. микроколонии с неровными краями ( «битое стекло» ); Ø Через 18 -24 час. – нежные плоские с темным зернистым центром и фестончатыми краями ( «кружевные платочки» ); Ø Зрелые колонии – через 40 -48 час. крупные колонии с бурым зернистым центром и неровными краями ( «ромашки» ).
Культуральные свойства Плотные питательные среды – три стадии роста: Ø Молодые колонии – через 10 -12 час. микроколонии с неровными краями ( «битое стекло» ); Ø Через 18 -24 час. – нежные плоские с темным зернистым центром и фестончатыми краями ( «кружевные платочки» ); Ø Зрелые колонии – через 40 -48 час. крупные колонии с бурым зернистым центром и неровными краями ( «ромашки» ).
 Биохимическая активность • Возбудитель расщепляет сахара до кислоты без газа. • По отношению к глицерину различают 2 варианта: Ø глицерин-позитивный (континентальный); Ø глицерин-негативный (океанический). • Не ферментирует лактозу, сахарозу и рамнозу. • Реакция Фогес-Поскауэра –. • Протеолитическая активность отсутствует.
Биохимическая активность • Возбудитель расщепляет сахара до кислоты без газа. • По отношению к глицерину различают 2 варианта: Ø глицерин-позитивный (континентальный); Ø глицерин-негативный (океанический). • Не ферментирует лактозу, сахарозу и рамнозу. • Реакция Фогес-Поскауэра –. • Протеолитическая активность отсутствует.
 Антигенная структура Антигены клеточной стенки: • О-антиген – соматический, ЛПС, эндотоксин; • ОСА – основной соматический антиген, белок, экзотоксин (гемолизин). Капсульные антигены: • F 1 -антиген – гликопептид (защищает от фагоцитоза, иммуногенные свойства); • VW – антиген вирулентности: V – белок, а W – липопротеин (антифагоцитарное действие, способствует внутриклеточному размножению). Внутри клетки: • Т-антиген – «мышиный» токсин, белок (блокирует функции митохондрий печени, селезенки, действие медиаторов, гормонов).
Антигенная структура Антигены клеточной стенки: • О-антиген – соматический, ЛПС, эндотоксин; • ОСА – основной соматический антиген, белок, экзотоксин (гемолизин). Капсульные антигены: • F 1 -антиген – гликопептид (защищает от фагоцитоза, иммуногенные свойства); • VW – антиген вирулентности: V – белок, а W – липопротеин (антифагоцитарное действие, способствует внутриклеточному размножению). Внутри клетки: • Т-антиген – «мышиный» токсин, белок (блокирует функции митохондрий печени, селезенки, действие медиаторов, гормонов).
 Факторы патогенности • Токсины: Ø Эндотоксин; Ø Экзотоксины – гемолизин (ОСА), «мышиный» токсин. • Ферменты: гиалуронидаза, нейроминидаза, лецитиназа, фибринолизин, плазмокоагулаза. • Структурные и химические компоненты клетки: пили I порядка, капсула, плазмиды, бактериоцины (пестицины).
Факторы патогенности • Токсины: Ø Эндотоксин; Ø Экзотоксины – гемолизин (ОСА), «мышиный» токсин. • Ферменты: гиалуронидаза, нейроминидаза, лецитиназа, фибринолизин, плазмокоагулаза. • Структурные и химические компоненты клетки: пили I порядка, капсула, плазмиды, бактериоцины (пестицины).
 Резистентность • Значительная устойчивость во внешней среде: Ø В воде, почве, на одежде – 1 -5 месяцев; Ø В трупах при низких температурах – длительное время; Ø В организме блох – до 1 года; Ø В гнойном содержимом бубонов – 20 -30 дней; Ø В мокроте – до 10 суток; Ø На овощах, фруктах – 6 -11 суток. • Чувствительны: Ø К УФЛ, высушиванию; Ø Повышенной температуре (600 С – 1 час, кипячение – 1 минута); Ø Действию дезинфиктантов (5% раствор карболовой кислоты – 5 -10 минут); Ø Антибиотикам (стрептомицину, тетрациклину, левомицитину, хлоранфениколу).
Резистентность • Значительная устойчивость во внешней среде: Ø В воде, почве, на одежде – 1 -5 месяцев; Ø В трупах при низких температурах – длительное время; Ø В организме блох – до 1 года; Ø В гнойном содержимом бубонов – 20 -30 дней; Ø В мокроте – до 10 суток; Ø На овощах, фруктах – 6 -11 суток. • Чувствительны: Ø К УФЛ, высушиванию; Ø Повышенной температуре (600 С – 1 час, кипячение – 1 минута); Ø Действию дезинфиктантов (5% раствор карболовой кислоты – 5 -10 минут); Ø Антибиотикам (стрептомицину, тетрациклину, левомицитину, хлоранфениколу).
 Эпидемиология Зооантропоноз (больные легочной формой). Резервуар и источник инфекции – грызуны: Ø в природе – сурки, суслики, песчанки, полевки; Ø в синантропных очагах – крысы, мыши. Механизмы передачи: Ø Трансмиссивный (путь – контаминационный, переносчики – блохи); Ø Контактный (путь – прямой контактный); Ø Аэрогенный (путь – воздушно-капельный, при легочной форме чумы).
Эпидемиология Зооантропоноз (больные легочной формой). Резервуар и источник инфекции – грызуны: Ø в природе – сурки, суслики, песчанки, полевки; Ø в синантропных очагах – крысы, мыши. Механизмы передачи: Ø Трансмиссивный (путь – контаминационный, переносчики – блохи); Ø Контактный (путь – прямой контактный); Ø Аэрогенный (путь – воздушно-капельный, при легочной форме чумы).
 Патогенез и клинические особенности Инкубационный период – 3 -6 суток. Патогенез чумы: 1. Внедрение возбудителя в организм в месте укуса блохи лимфоузлы (подмышечные и паховые) некрозно-геморрагическое воспаление (бубоны). 2. Бактериемия. 3. Диссеминация по органам.
Патогенез и клинические особенности Инкубационный период – 3 -6 суток. Патогенез чумы: 1. Внедрение возбудителя в организм в месте укуса блохи лимфоузлы (подмышечные и паховые) некрозно-геморрагическое воспаление (бубоны). 2. Бактериемия. 3. Диссеминация по органам.
 Клинические формы чумы: • • • Кожная; Бубонная; Легочная; Кишечная; Септическая. Постинфекционный иммунитет – клеточный, напряженный, пожизненный.
Клинические формы чумы: • • • Кожная; Бубонная; Легочная; Кишечная; Септическая. Постинфекционный иммунитет – клеточный, напряженный, пожизненный.
 Микробиологическая диагностика Исследуемый материал – отделяемое или пунктат бубонов, язв, мокрота, слизь из зева, мазок с миндалин, испражнения, кровь, секционный материал и др. • • • Бактериоскопический метод. Бактериологический метод (основной). Биологический. Серологический – РПГА, РИФ, ИФА. Молекулярно-биологический метод – ПЦР, ДНКзонды.
Микробиологическая диагностика Исследуемый материал – отделяемое или пунктат бубонов, язв, мокрота, слизь из зева, мазок с миндалин, испражнения, кровь, секционный материал и др. • • • Бактериоскопический метод. Бактериологический метод (основной). Биологический. Серологический – РПГА, РИФ, ИФА. Молекулярно-биологический метод – ПЦР, ДНКзонды.
 Специфическая профилактика. Вакцинация по эпидпоказаниям: живой аттенуированной вакциной из штамма EV или химической вакциной. Специфическое лечение – противочумной иммуноглобулин.
Специфическая профилактика. Вакцинация по эпидпоказаниям: живой аттенуированной вакциной из штамма EV или химической вакциной. Специфическое лечение – противочумной иммуноглобулин.
 Бруцеллез – зоонозное инфекционноаллергическое заболевание, характеризующееся длительной лихорадкой, поражением опорнодвигательного аппарата, нервной, сердечно-сосудистой, мочеполовой и других систем организма. Имеет склонность к затяжному, хроническому течению.
Бруцеллез – зоонозное инфекционноаллергическое заболевание, характеризующееся длительной лихорадкой, поражением опорнодвигательного аппарата, нервной, сердечно-сосудистой, мочеполовой и других систем организма. Имеет склонность к затяжному, хроническому течению.
 Историческая справка • 1886 г. : Д. Брюс обнаружил В. melitensis в мазках из селезенки погибшего от бруцеллеза больного. • 1897 г. : Б. Банг и Б. Стрибольт – выделили из околоплодной жидкости коров B. abortus. • 1914 г. : Д. Траум – обнаружил аналогичных возбудителей у свиней – B. suis. • 1957 г. – B. neatomae (от кустарниковых крыс). • 1960 г. – B. canis (от гончих собак). • 1970 г. – B. ovis (от барана).
Историческая справка • 1886 г. : Д. Брюс обнаружил В. melitensis в мазках из селезенки погибшего от бруцеллеза больного. • 1897 г. : Б. Банг и Б. Стрибольт – выделили из околоплодной жидкости коров B. abortus. • 1914 г. : Д. Траум – обнаружил аналогичных возбудителей у свиней – B. suis. • 1957 г. – B. neatomae (от кустарниковых крыс). • 1960 г. – B. canis (от гончих собак). • 1970 г. – B. ovis (от барана).
 Таксономия • Семейство – Brucellaceae • Род – Brucella • Виды – В. melitensis B. abortus B. suis B. canis B. ovis B. neatomae
Таксономия • Семейство – Brucellaceae • Род – Brucella • Виды – В. melitensis B. abortus B. suis B. canis B. ovis B. neatomae
 Морфология • • Кокковидные палочки; Размеры – 0, 5 -0, 7× 0, 6 -1, 5; Грамотрицательные; В мазках – беспорядочно; Неподвижны; Спор не образуют; Могут образовывать капсулу.
Морфология • • Кокковидные палочки; Размеры – 0, 5 -0, 7× 0, 6 -1, 5; Грамотрицательные; В мазках – беспорядочно; Неподвижны; Спор не образуют; Могут образовывать капсулу.
 Культуральные свойства • • • Строгие аэробы; Температура – 370 С; р. Н 6, 8 -7, 2; У B. abortus потребность в 5 -10% СО 2; . Медленный рост – 1 -3 недели; Требовательны к питательным средам (печеночный, сывороточный, кровяной агар); • В жидкой среде – диффузное помутнение; • На плотных питательных средах – бесцветные мелкие выпуклые гладкие колонии с нежной зернистостью.
Культуральные свойства • • • Строгие аэробы; Температура – 370 С; р. Н 6, 8 -7, 2; У B. abortus потребность в 5 -10% СО 2; . Медленный рост – 1 -3 недели; Требовательны к питательным средам (печеночный, сывороточный, кровяной агар); • В жидкой среде – диффузное помутнение; • На плотных питательных средах – бесцветные мелкие выпуклые гладкие колонии с нежной зернистостью.
 Биохимическая активность • Ферментируют глюкозу и арабинозу до кислоты без газа. • Восстанавливают нитраты. • Образуют Н 2 S. • Индол не образуют.
Биохимическая активность • Ферментируют глюкозу и арабинозу до кислоты без газа. • Восстанавливают нитраты. • Образуют Н 2 S. • Индол не образуют.
 Видовые различия бруцелл Виды бруцелл Рост на средах с красителями Образование Потребность Н 2 S в СО 2 фуксино м В. melitensis (3 биовара) B. abortus (9 биоваров) B. suis (5 биоваров) тионином + + - - + + -
Видовые различия бруцелл Виды бруцелл Рост на средах с красителями Образование Потребность Н 2 S в СО 2 фуксино м В. melitensis (3 биовара) B. abortus (9 биоваров) B. suis (5 биоваров) тионином + + - - + + -
 Антигенная структура • • Соматические антигены: Ø М-антиген – у В. melitensis, Ø А-антиген – у B. abortus и B. suis. L(Vi)-антиген – поверхностно расположенный антиген вирулентности.
Антигенная структура • • Соматические антигены: Ø М-антиген – у В. melitensis, Ø А-антиген – у B. abortus и B. suis. L(Vi)-антиген – поверхностно расположенный антиген вирулентности.
 Факторы патогенности • Токсины: эндотоксин. • Ферменты: гиалуронидаза и нейроминидаза. • Структурные и химические компоненты клетки: пили I порядка, белки клеточной стенки, капсула. • Высокая инвазивность. • Факультативные внутриклеточные паразиты.
Факторы патогенности • Токсины: эндотоксин. • Ферменты: гиалуронидаза и нейроминидаза. • Структурные и химические компоненты клетки: пили I порядка, белки клеточной стенки, капсула. • Высокая инвазивность. • Факультативные внутриклеточные паразиты.
 Резистентность • Бруцеллы устойчивы во внешней среде: Ø В воде и влажной почве – до 5 месяцев; Ø В молоке – 9 месяцев; Ø В сыре – до 1 года; Ø В замороженном мясе – до 5 месяцев. • Чувствительны: Ø 600 С – 30 минут, кипячение – мгновенно; Ø 3% раствор хлорной извести, 1% хлорамин, 2% формалин – 5 минут; Ø антибиотикам (стрептомицину, тетрациклину, рифампицину).
Резистентность • Бруцеллы устойчивы во внешней среде: Ø В воде и влажной почве – до 5 месяцев; Ø В молоке – 9 месяцев; Ø В сыре – до 1 года; Ø В замороженном мясе – до 5 месяцев. • Чувствительны: Ø 600 С – 30 минут, кипячение – мгновенно; Ø 3% раствор хлорной извести, 1% хлорамин, 2% формалин – 5 минут; Ø антибиотикам (стрептомицину, тетрациклину, рифампицину).
 Эпидемиология • Зооноз. • Резервуар и источник инфекции – больные домашние животные: овцы, козы, свиньи, КРС. • Механизмы передачи: Ø Фекально-оральный (путь – алиментарный – сырое молоко, сыр); Ø Контактный (путь – прямой контактный); Ø Аэрогенный (путь – воздушно-пылевой). • Профессиональный характер. • Инкубационный период – 1 -4 недели.
Эпидемиология • Зооноз. • Резервуар и источник инфекции – больные домашние животные: овцы, козы, свиньи, КРС. • Механизмы передачи: Ø Фекально-оральный (путь – алиментарный – сырое молоко, сыр); Ø Контактный (путь – прямой контактный); Ø Аэрогенный (путь – воздушно-пылевой). • Профессиональный характер. • Инкубационный период – 1 -4 недели.
 Патогенез и клинические особенности • Бруцеллы проникают в организм через слизистые или кожные покровы региональные лимфоузлы фагоцитоз формируют L-формы. • Бактериемия. • Диссиминируют в печень, селезенку, почки, костный мозг, суставы, эндокард (очаги некроза, окруженые инфильтратами). Постинфекционный иммунитет – гуморальный (неполные антитела) и клеточный, нестойкий, нестерильный, формируется ГЗТ.
Патогенез и клинические особенности • Бруцеллы проникают в организм через слизистые или кожные покровы региональные лимфоузлы фагоцитоз формируют L-формы. • Бактериемия. • Диссиминируют в печень, селезенку, почки, костный мозг, суставы, эндокард (очаги некроза, окруженые инфильтратами). Постинфекционный иммунитет – гуморальный (неполные антитела) и клеточный, нестойкий, нестерильный, формируется ГЗТ.
 Микробиологическая диагностика Исследуемый материал – кровь, желчь, моча, пунктат костного мозга, молоко. • Бактериоскопический метод. • Бактериологический метод. • Биологический. • Серологический – РА (реакция Хеддельсона, Райта), РПГА, РИФ, ИФА, РСК, реакция Кумбса, кольцевая проба Банга для выявления возбудителя в молоке. • Аллергологический – проба Бюрне. • Молекулярно-биологический метод – ПЦР.
Микробиологическая диагностика Исследуемый материал – кровь, желчь, моча, пунктат костного мозга, молоко. • Бактериоскопический метод. • Бактериологический метод. • Биологический. • Серологический – РА (реакция Хеддельсона, Райта), РПГА, РИФ, ИФА, РСК, реакция Кумбса, кольцевая проба Банга для выявления возбудителя в молоке. • Аллергологический – проба Бюрне. • Молекулярно-биологический метод – ПЦР.
 Специфическая профилактика. Вакцинация по эпидпоказаниям: живой вакциной из аттенуированного штамма B. abortus. Специфическое лечение – противобруцеллезный иммуноглобулин, хронических форм – убитая бруцеллезная вакцина.
Специфическая профилактика. Вакцинация по эпидпоказаниям: живой вакциной из аттенуированного штамма B. abortus. Специфическое лечение – противобруцеллезный иммуноглобулин, хронических форм – убитая бруцеллезная вакцина.
 Туляремия – острое природно-очаговое зоонозное заболевание, характеризующееся лихорадкой, образованием лимфаденитов и поражением различных органов (глаз, легких, кожных покровов, ЖКТ и др. )
Туляремия – острое природно-очаговое зоонозное заболевание, характеризующееся лихорадкой, образованием лимфаденитов и поражением различных органов (глаз, легких, кожных покровов, ЖКТ и др. )
 Историческая справка • 1911 г: Г. Мак-Кой и Ш. Чепин – выделили возбудителя туляремии. • Э. Френсис – подробно изучил свойства.
Историческая справка • 1911 г: Г. Мак-Кой и Ш. Чепин – выделили возбудителя туляремии. • Э. Френсис – подробно изучил свойства.
 Таксономия • Семейство – Brucellaceae • Род – Francisella • Виды – Francisella tularensis
Таксономия • Семейство – Brucellaceae • Род – Francisella • Виды – Francisella tularensis
 Морфология • • Кокковидные палочки; Размеры – 0, 2 -0, 7× 0, 2 мкм; Грамотрицательные; В мазках – беспорядочно; Неподвижные; Спор не образуют; Имеют капсулу.
Морфология • • Кокковидные палочки; Размеры – 0, 2 -0, 7× 0, 2 мкм; Грамотрицательные; В мазках – беспорядочно; Неподвижные; Спор не образуют; Имеют капсулу.
Культуральные свойства • • • Строгие аэробы; Температура – 370 С; р. Н 6, 8 -7, 2; Рост замедленный – 3 -5 суток; Требовательны к питательным средам: среды с добавлением яичного желтка (среда Мак-Коя), крови, цистина и глюкозы; • В жидких средах – пленка; • На плотных – крупные нежные молочно-белые колонии с ровным краем.
Культуральные свойства • • • Строгие аэробы; Температура – 370 С; р. Н 6, 8 -7, 2; Рост замедленный – 3 -5 суток; Требовательны к питательным средам: среды с добавлением яичного желтка (среда Мак-Коя), крови, цистина и глюкозы; • В жидких средах – пленка; • На плотных – крупные нежные молочно-белые колонии с ровным краем.
 Биохимическая активность • Ферментируют глюкозу, мальтозу, маннит, фруктозу и другие сахара до кислоты. • По отношению к глицерину и распространению – 3 географические расы Francisella tularensis: Ø Голарктическая – глицерин – , умеренно патогенна (Европа, Азия); Ø Среднеазиатская – глицерин + , умеренно патогенна (РФ); Ø Неарктическая – глицерин + , высоко патогенна (Северная Америка); • Образуют аммиак, Н 2 S; • Индол не образуют.
Биохимическая активность • Ферментируют глюкозу, мальтозу, маннит, фруктозу и другие сахара до кислоты. • По отношению к глицерину и распространению – 3 географические расы Francisella tularensis: Ø Голарктическая – глицерин – , умеренно патогенна (Европа, Азия); Ø Среднеазиатская – глицерин + , умеренно патогенна (РФ); Ø Неарктическая – глицерин + , высоко патогенна (Северная Америка); • Образуют аммиак, Н 2 S; • Индол не образуют.
 Антигенная структура • • О-антиген – соматический, ЛПС КС. Vi-антиген – разновидность капсульного антигена, вирулентные и иммуногенные свойствами. Факторы патогенности Токсины: эндотоксин. Ферменты: гиалуронидаза, нейроминидаза, фибринолизин. Структурные и химические компоненты клетки: пили I порядка, белки клеточной стенки, капсула.
Антигенная структура • • О-антиген – соматический, ЛПС КС. Vi-антиген – разновидность капсульного антигена, вирулентные и иммуногенные свойствами. Факторы патогенности Токсины: эндотоксин. Ферменты: гиалуронидаза, нейроминидаза, фибринолизин. Структурные и химические компоненты клетки: пили I порядка, белки клеточной стенки, капсула.
 Резистентность • Хорошо сохраняется во внешней среде: Ø В воде, почве при +40 С – до 4 месяцев; Ø На зерне при +10 С – 9 месяцев, при 20 -250 С – 1 -2 мес; Ø В шкурах животных – до 1 месяца. • Чувствительны Ø к повышенной температуре (600 С – 20 минут; кипячение – 1 -2 минуты); Ø действию дезинфиктантов (5% формалин – 2 -5 минут); Ø антибиотикам (стрептомицину, тетрациклину, гентамицину, канамицину).
Резистентность • Хорошо сохраняется во внешней среде: Ø В воде, почве при +40 С – до 4 месяцев; Ø На зерне при +10 С – 9 месяцев, при 20 -250 С – 1 -2 мес; Ø В шкурах животных – до 1 месяца. • Чувствительны Ø к повышенной температуре (600 С – 20 минут; кипячение – 1 -2 минуты); Ø действию дезинфиктантов (5% формалин – 2 -5 минут); Ø антибиотикам (стрептомицину, тетрациклину, гентамицину, канамицину).
 Эпидемиология • Зооноз. • Резервуар и источник инфекции – грызуны. • Механизмы передачи: Ø Трансмиссивный (переносчик – иксодовые клещи); Ø Фекально-оральный (путь – алиментарный и водный); Ø Контактный (путь – прямой контактный); Ø Аэрогенный (путь – воздушно-пылевой). • Инкубационный период – 2 -8 дней.
Эпидемиология • Зооноз. • Резервуар и источник инфекции – грызуны. • Механизмы передачи: Ø Трансмиссивный (переносчик – иксодовые клещи); Ø Фекально-оральный (путь – алиментарный и водный); Ø Контактный (путь – прямой контактный); Ø Аэрогенный (путь – воздушно-пылевой). • Инкубационный период – 2 -8 дней.
 Патогенез и клинические особенности 1. Проникновение в организм человека, в области входных ворот – первичный аффект: пятно папула везикула пустула язвочка. 2. Поражение лимфоузлов фагоцитоз размножение. 3. Бактериемия. 4. Стадия очаговых поражений с образованием гранулем (селезенка, печень, легкие, костный мозг). Клинические формы заболевания: • Бубонная; • Легочная; • Желудочно-кишечная.
Патогенез и клинические особенности 1. Проникновение в организм человека, в области входных ворот – первичный аффект: пятно папула везикула пустула язвочка. 2. Поражение лимфоузлов фагоцитоз размножение. 3. Бактериемия. 4. Стадия очаговых поражений с образованием гранулем (селезенка, печень, легкие, костный мозг). Клинические формы заболевания: • Бубонная; • Легочная; • Желудочно-кишечная.
 Иммунитет Постинфекционный иммунитет – гуморальный и клеточный, стойкий, пожизненный.
Иммунитет Постинфекционный иммунитет – гуморальный и клеточный, стойкий, пожизненный.
 Микробиологическая диагностика Исследуемый материал – пунктат из бубонов, отделяемое конъюктивы, мокрота, слизь из зева, кровь, испражнения, ткани погибших грызунов. • • • Бактериоскопический метод. Бактериологический метод (основной). Биологический. Серологический – РА, РИФ. Аллергологический – проба с тулярином. Молекулярно-биологический метод – ПЦР.
Микробиологическая диагностика Исследуемый материал – пунктат из бубонов, отделяемое конъюктивы, мокрота, слизь из зева, кровь, испражнения, ткани погибших грызунов. • • • Бактериоскопический метод. Бактериологический метод (основной). Биологический. Серологический – РА, РИФ. Аллергологический – проба с тулярином. Молекулярно-биологический метод – ПЦР.
 Специфическая профилактика. Вакцинация по эпидпоказаниям: живой аттенуированной туляремийной вакциной. Специфическое лечение – не применяется.
Специфическая профилактика. Вакцинация по эпидпоказаниям: живой аттенуированной туляремийной вакциной. Специфическое лечение – не применяется.
 • Список литературы: • 1. Авдеев М. И. Судебно-медицинская экспертиза трупа, М. , 1976; • 2. Петров С. В. Общая хирургия: учебник(2 -е изд). - СПб: Питер, 2003. - 768 с. - Серия «Национальная медицинская библиотека» ). • 3. Струков А. И. , Серов В. В. Патологическая анатомия: Учебник. - 4 -е изд. , стереотипное. - М. : Медицина, 1995. - 668 с. , ил. • 4. Шалевич М. А. ; Буромский И. В. Судебномедицинская экспертиза трупа, М. , 1983 • 5. По материалам сайта http: //www. labex. ru/page/sudmed_111. html
• Список литературы: • 1. Авдеев М. И. Судебно-медицинская экспертиза трупа, М. , 1976; • 2. Петров С. В. Общая хирургия: учебник(2 -е изд). - СПб: Питер, 2003. - 768 с. - Серия «Национальная медицинская библиотека» ). • 3. Струков А. И. , Серов В. В. Патологическая анатомия: Учебник. - 4 -е изд. , стереотипное. - М. : Медицина, 1995. - 668 с. , ил. • 4. Шалевич М. А. ; Буромский И. В. Судебномедицинская экспертиза трупа, М. , 1983 • 5. По материалам сайта http: //www. labex. ru/page/sudmed_111. html
 Благодарю за внимание
Благодарю за внимание


